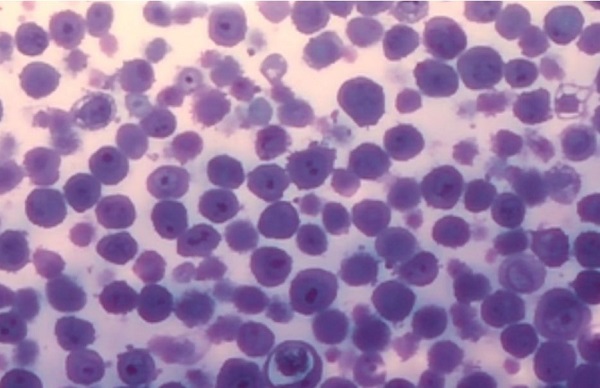
Новосибирские ученые представили препарат для терапии воспаления внутренних органов Новосибирские ученые представили препарат для терапии воспаления внутренних органов

Научные сотрудники лаборатории экспериментальной и клинической фармакологии НИИКЭЛ – филиал ИЦиГ СО РАН разработали прототип лекарственного средства на основе тестикулярной гиалуронидазы. Лекарственное средство обладает антиоксидантным, противовоспалительным и иммуномодулирующим действиями. Особенностью разработки стала более удобная по сравнению с существующими аналогами форма выпуска: в виде таблеток или капсул. Об этом сообщает пресс-служба Института цитологии и генетики СО РАН.
Гиалуронидазы — семейство ферментов, расщепляющих гиалуроновую кислоту (основной субстрат соединительной ткани) на моносахариды. В организме человека гиалуронидазы присутствуют во многих органах и жидкостях. В медицине препараты гиалуронидазы применяются на протяжении полувека при заболеваниях, сопровождающихся ростом соединительной ткани, а также для увеличения биодоступности лекарств и вакцин. Однако в настоящее время такие препараты выпускаются только в виде свечей и растворов для внутримышечного введения или ингаляций. Идея ученых НИИКЭЛ заключалась в том, чтобы создать препарат в виде таблеток или капсул, который пациентам будет удобно принимать самостоятельно.
«Разработанный нами прототип лекарственного средства – это тестикулярная гиалуронидаза H20, подвергнутая электронно-лучевой иммобилизации на полиэтиленгликоле – пегилированная гиалуронидаза (ПЭГ-ГИАЛ). Иммобилизация понадобилась для того, чтобы избежать возможного аллергического действия, которым обладают многие препараты белкового происхождения, а также для увеличения стабильности препарата на основе ферментов (в чистом виде такие препараты быстро выводятся из организма)», – рассказывает младший научный сотрудник лаборатории экспериментальной и клинической фармакологии Александра Швецова.
ПЭГ-ГИАЛ представляет собой высушенный особым способом порошок светло-серого цвета. После проведения доклинических и клинических исследований порошку можно будет придать нужную форму (таблетки или капсулы).
Иммобилизированная гиалуронидаза обладает антиоксидантным, хелатирующим, противовоспалительным и иммуномодулирующим действиями. Такой препарат может не только изменять структуру сформированных соединительно-тканных образований – спаек, рубцов, фиброзную ткань, но и способствовать снижению интенсивности их формирования. Под воздействием препарата уменьшается отечность ткани и происходит реконструкция самого межклеточного матрикса. Участки зарубцевавшейся ткани при этом становятся эластичнее, размягчаются и уплощаются. А подавляя воспалительный процесс, препарат устраняет причину разрастания соединительной ткани. Эксперименты уже подтвердили хороший противовоспалительный эффект разрабатываемого препарата.
Сейчас препарат проходит доклиническую оценку безопасности. Ученые уже оценили острую и субхроническую токсичность препарата на культуре клеток и на животных. Затем предстоит проверить патофизиологическое действие: на животных моделях ученые посмотрят, оказывает ли препарат положительное влияние на печень, поджелудочную железу и кровеносные сосуды при старении.
После успешного проведения всего комплекса доклинических исследований ученые смогут перейти к следующей фазе – клиническим испытаниям препарата. В перспективе разработка новосибирских ученых может применяться при острых панкреатитах, при лечении хронического гепатита и дистрофических заболеваниях печени, а также в терапии последствий легочных заболеваний и в офтальмологии для более тонкого рубцевания пораженных участков роговицы, при разных видах ретинопатии.
Первые результаты своей работы над прототипом лекарственного средства на основе тестикулярной гиалуронидазы научные сотрудники НИИИКЭЛ представили на 14-й Международной конференции «Биоинформатике регуляции и структуры геномов / системная биология» (Bioinformatics of Genome Regulation and Structure\Systems Biology, BGRS\SB-2024).
Разработка молодых ученых включена в государственное задание молодежной лаборатории в составе СибБИОНОЦ.